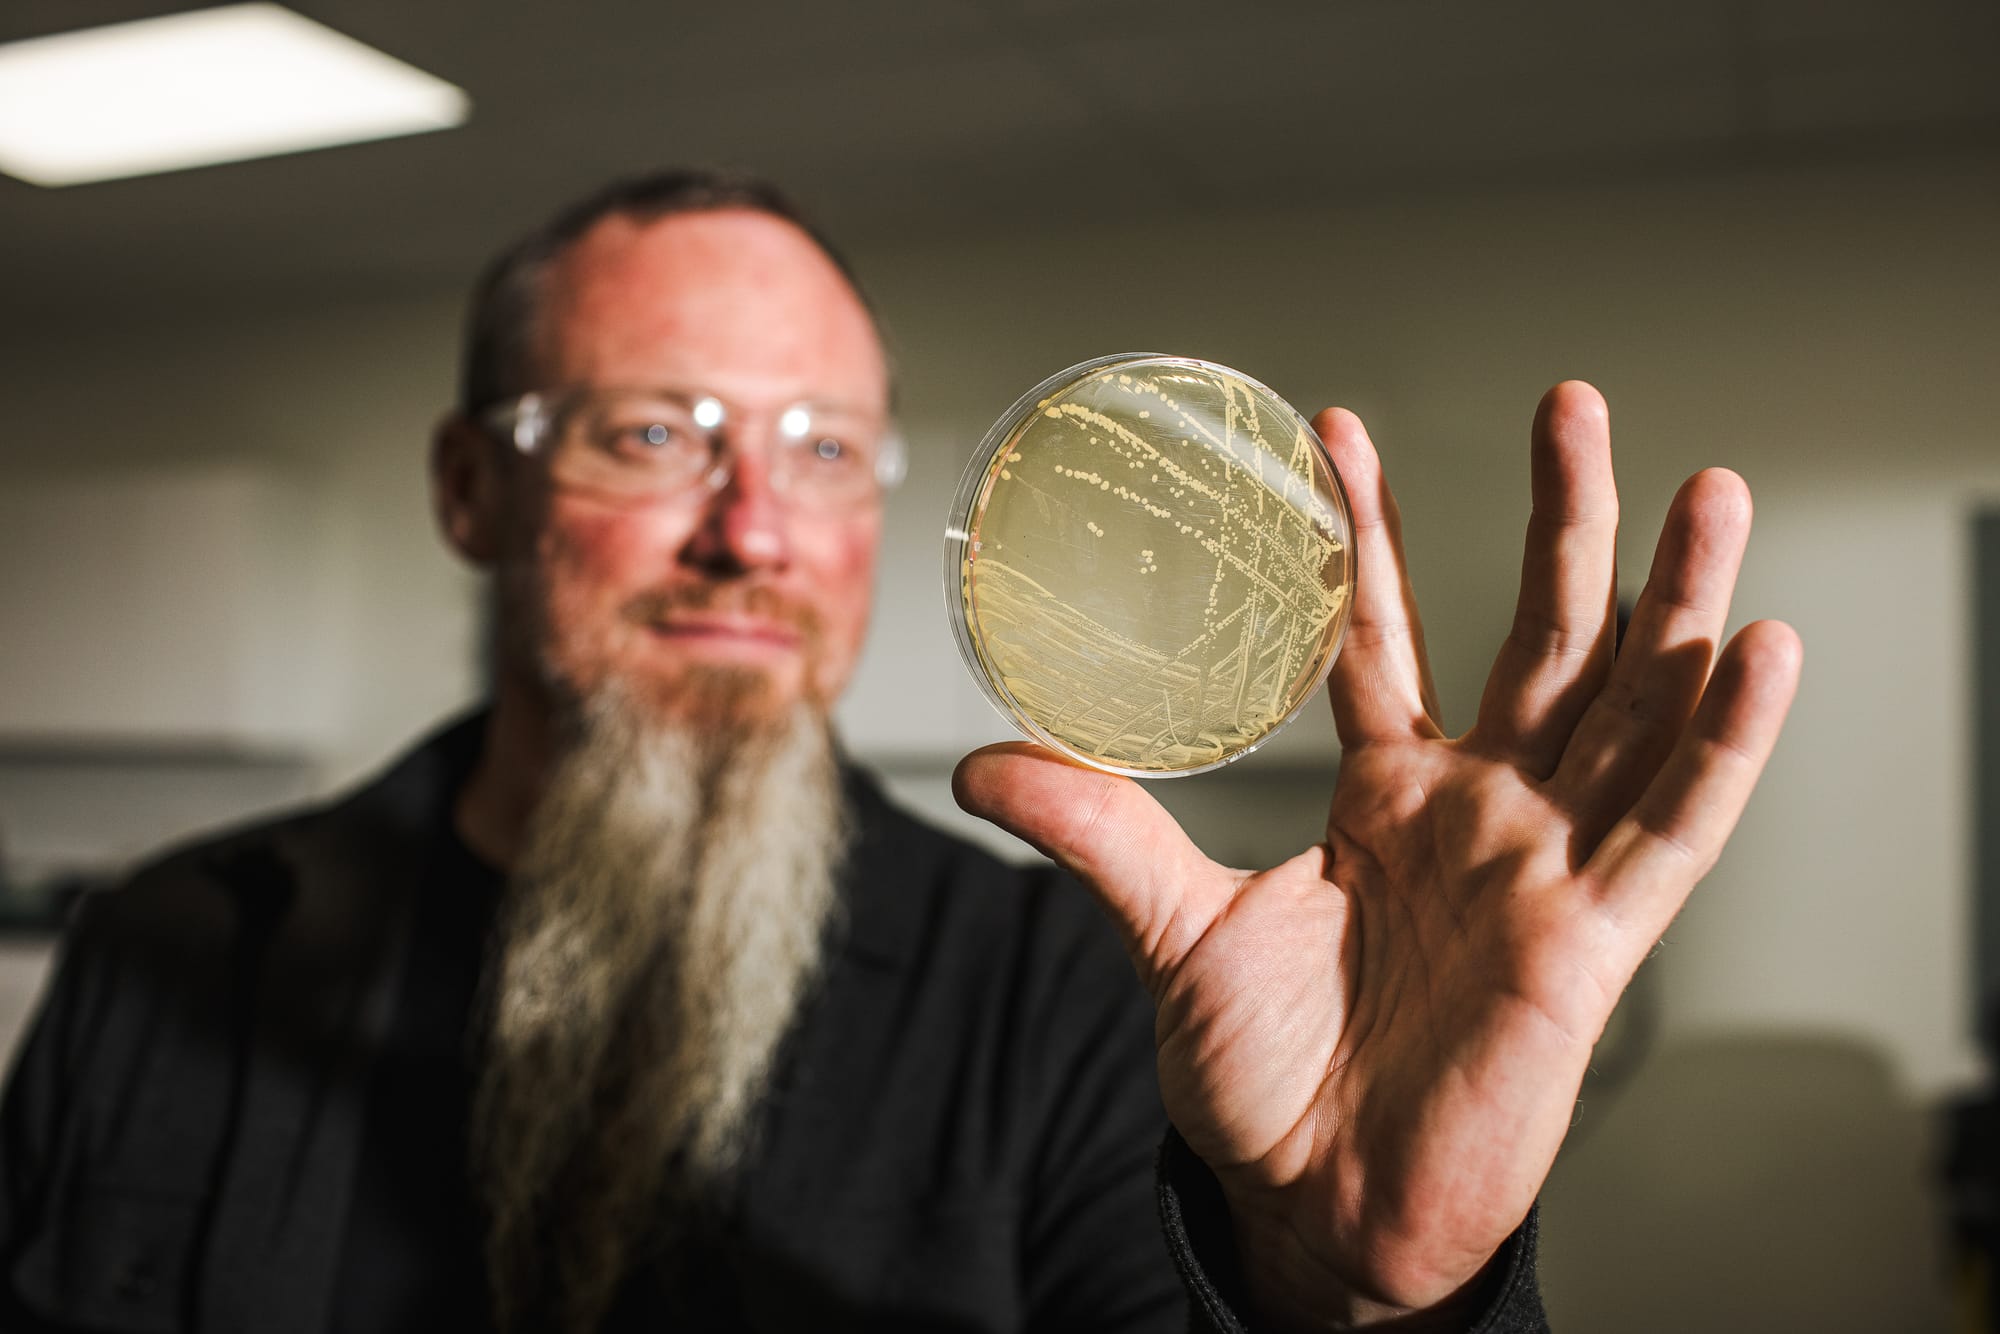

Sustainability at Wilderness Trail Distillery
I’ve been to dozens of bourbon distilleries, and I can confidently say that Wilderness Trail is truly built differently. Everything they do is underpinned by expertise and near fanaticism for science.

I’m often asked, “What’s a bourbon you’re really excited about right now?” or “What distillery should I be watching?” I love this question because it implies a true curiosity and a desire to try something new and potentially off the beaten path. When Bill Thomas, owner of the world-famous Jack Rose whiskey bar in Washington, DC, first introduced me to Wilderness Trail in 2020, the distillery became my go-to response to this question. It has also remained a stalwart favorite for my home bar.
I’ve been to dozens of bourbon distilleries, and I can confidently say that Wilderness Trail is truly built differently. Everything they do is underpinned by expertise and near fanaticism for science. And it’s all due to the man behind the magic: Dr. Pat Heist. This funky-bearded, Slayer-loving, yeast-obsessed, country-talking dude is easily the smartest man I’ve ever met in my over ten years writing about bourbon. With a PhD in Plant Pathology and a degree in Microbiology, Dr. Pat knows his stuff and wants to ensure you learn about it, too.
Wilderness Trail is the brainchild of Dr. Pat, band buddy, and fellow scientist Shane. The two started out with their yeast business - Ferm Solutions - to become the best and most respected dudes in yeast. They’ve been to hundreds of distilleries - both commercial (like fuel alcohol) and consumer-focused (like booze) - helping them expertly solve any challenges related to the unsung hero (and much-maligned villain when things go wrong) of the distillation process: yeast. So, being two guys who really knew their stuff and just so happened to be “bourbon fans first and foremost," they decided, “Why not?” and opened a distillery. The goal? “Make the best whiskey the world has ever seen.” And readers, they are very well on their way.
Everything at Wilderness Trail is excellent. I’ve never had a bad pour from a bottle of theirs, including the thieved taste I recently was honored to try of the first barrel of distillate they laid down on October 31, 2013. It’s truly expertly crafted with the utmost attention to how yeast and the fermentation process impact the flavor of the final product. Science informs every step here. But beyond the science of distillation, what I may love even more about Wilderness Trail is the unfaltering dedication to constant innovation. The consistency in the quality of the whiskey is a testament to this commitment.
A key part of innovation at Wilderness Trail is how to operate in a more environmentally friendly way. As someone who works full-time in the renewables and climate space (gotta pay the bills, and I love working for a good cause), I was particularly intrigued by the sustainability efforts of the distillery. Many distilleries tout climate-friendly efforts, such as focusing on sourcing grain from as close to the facility as possible, which supports local agriculture and reduces emissions from trucking. Though Wilderness Trail also tries to stay local, these science-minded folks are making even greater strides towards sustainable operations, particularly water and energy use.
Ultra Filtration
Water is a huge part of the distillation process. It doesn’t take much in terms of basic inputs to make a whiskey: you mainly need grain, water, and yeast, with grain and water (stillage) as the main byproducts of the process. Many distilleries send off this grain waste to nearby farmers as livestock feed, as it is nutritious and cheap. But this wasn’t good enough for Dr. Pat.
Each day, Wilderness Trail churns out 100K gallons of stillage. And a lot of this is water: water that can be cleaned and reused in the whiskey-making process. Instead of sending off this waste to farmers as is, the byproduct is routed through an Ultra Filtration (UF) system that separates the water from the solids, resulting in a much dryer grain product that allows farmers to transport more calorific content further due to its enhanced stability. The dryer it is, the longer it can last without spoiling. This way, the love can be spread further and wider and there is no risk of over-saturating (and potentially generating waste) the surrounding areas with a glut of feed.
And all that water? It’s run through a reverse osmosis process and reused for fermenter water. This innovation conserves water, reduces their water spend, and makes their stillage byproduct more desirable. In short, it's good for the environment, the bottom line, and farmers. A model other distilleries should seek to replicate.
Optimized Mash Cook Temperature
The second way the distillery reduces its carbon footprint is by lowering the heat of the mash cooking process. Cooking grain mash seeks to gelatinize the corn starch; you need a lot of heat to achieve that. However, in examining exactly how much heat was needed to achieve the desired result, they learned it's less than most distilleries default to. Wilderness Trail cooks their mash to 185 degrees, thus saving energy, again good for the planet and the P&L.
So, if you haven’t tried Wilderness Trail yet, I highly recommend it. My favorite product is the Rye Whiskey, which boasts a gorgeous spearmint taste. Their Wheated Bourbon, which imparts a pleasant flavor of Juicy Fruit, is also much more readily available (and IMO, better) than some of the other more sought-after wheated expressions on the market.

